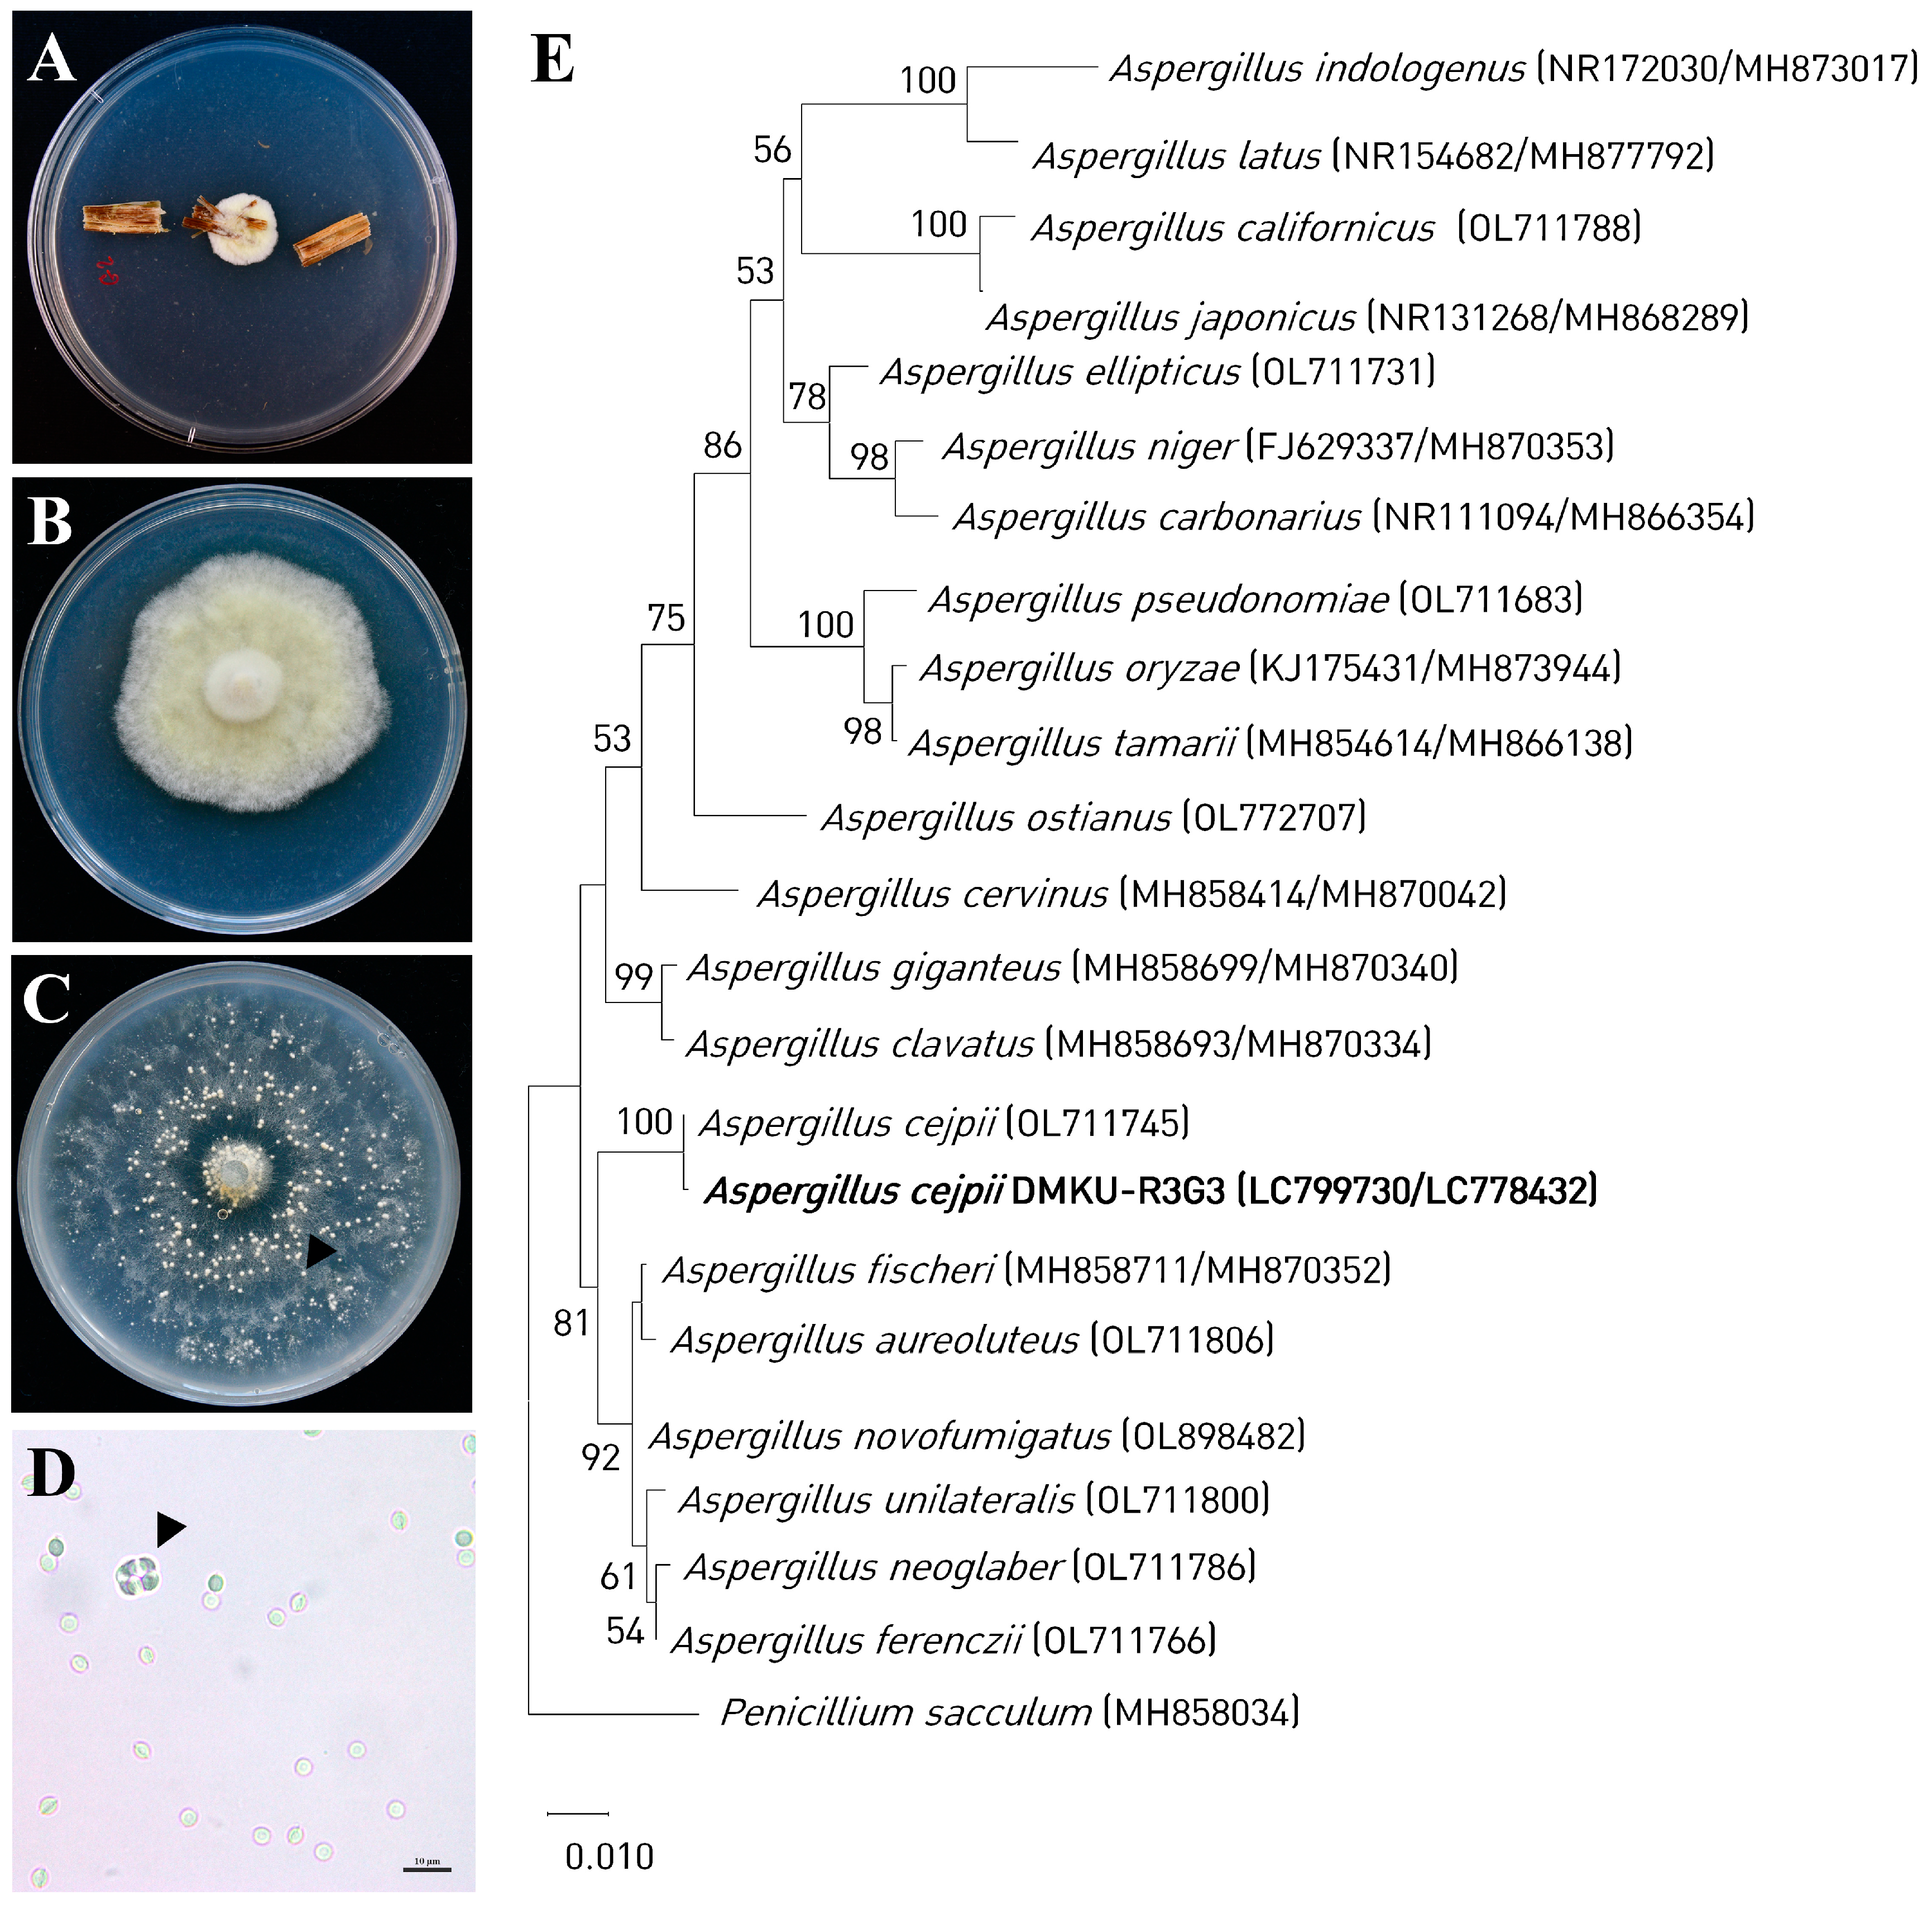
Agronomy 14 00498 g001

Exploring the Impact of Endophytic Fungus Aspergillus cejpii DMKU-R3G3 on Rice: Plant Growth Promotion and Molecular Insights through Proteomic Analysis
Abstract
1. Introduction
2. Materials and Methods
2.1. Endophytic Fungal Isolation
2.2. Fungal Identification
2.3. IAA Production
2.4. Phosphate Solubilization
2.5. Co-Cultivation of Endophytic Fungus DMKU-R3G3 with Rice
2.6. Protein Extraction
2.7. Protein Digestion
2.8. Liquid Chromatography–Tandem Mass Spectrometry (LC-MS/MS)
2.9. Protein Identification
3. Results
3.1. Isolation and Identification of Endophytic Fungus DMKU-R3G3
3.2. Indole-3-Acetic Acid (IAA) Production
3.3. Phosphate Solubilization
3.4. Evaluation of the Efficacy of Endophytic Fungus DMKU-R3G3 in Promoting Rice Growth
3.5. Proteome Analysis
4. Discussion
5. Conclusions
Supplementary Materials
Author Contributions
Funding
Institutional Review Board Statement
Informed Consent Statement
Data Availability Statement
Acknowledgments
Conflicts of Interest
References
- Zibaee, A. Rice: Importance and Future. J. Rice Res. 2013, 1, e102. [Google Scholar] [CrossRef]
- Chen, T.-Y.C.; Chiou, T.-Y.; Delgado, A.L.; Liao, C.-S. The Control of Rice Blast Disease by the Novel Biofungicide Formulations. Sustainability 2019, 11, 3449. [Google Scholar] [CrossRef]
- Dos Reis, J.B.A.; Lorenzi, A.S.; do Vale, H.M.M. Methods used for the study of endophytic fungi: A review on methodologies and challenges, and associated tips. Arch. Microbiol. 2022, 204, 675. [Google Scholar] [CrossRef]
- Wen, J.; Okyere, S.K.; Wang, S.; Wang, J.; Xie, L.; Ran, Y.; Hu, Y. Endophytic Fungi: An Effective Alternative Source of Plant-Derived Bioactive Compounds for Pharmacological Studies. J. Fungi 2022, 8, 205. [Google Scholar] [CrossRef]
- Leewijit, T.; Pongnak, W.; Soytong, K.; Poeaim, S. Isolation of Soil and Endophytic Fungi from Rice (Oryza sativa L.). Int. J. Agric. Technol. 2016, 12, 2191–2202. [Google Scholar]
- Potshangbam, M.; Devi, S.I.; Sahoo, D.; Strobel, G.A. Functional Characterization of Endophytic Fungal Community Associated with Oryza sativa L. and Zea mays L. Front. Microbiol. 2017, 8, 325. [Google Scholar] [CrossRef] [PubMed]
- Phan, L.T.K.; Tran, T.M.; Audenaert, K.; Jacxsens, L.; Eeckhout, M. Contamination of Fusarium proliferatum and Aspergillus flavus in the Rice Chain Linked to Crop Seasons, Cultivation Regions, and Traditional Agricultural Practices in Mekong Delta, Vietnam. Foods 2021, 10, 2064. [Google Scholar] [CrossRef] [PubMed]
- Ye, B.; Wu, Y.; Zhai, X.; Zhang, R.; Wu, J.; Zhang, C.; Rahman, K.; Qin, L.; Han, T.; Zheng, C. Beneficial Effects of Endophytic Fungi from the Anoectochilus and Ludisia Species on the Growth and Secondary Metabolism of Anoectochilus roxburghii. ACS Omega 2020, 5, 3487–3497. [Google Scholar] [CrossRef] [PubMed]
- Atugala, D.M.; Deshappriya, N. Effect of endophytic fungi on plant growth and blast disease incidence of two traditional rice varieties. J. Natl. Sci. Found. Sri Lanka 2015, 43, 173–187. [Google Scholar] [CrossRef]
- Hung, R.; Lee Rutgers, S. Applications of Aspergillus in Plant Growth Promotion. In New and Future Developments in Microbial Biotechnology and Bioengineering; Elsevier: Amsterdam, The Netherlands, 2016; pp. 223–227. [Google Scholar] [CrossRef]
- Lubna, S.A.; Hamayun, M.; Gul, H.; Lee, I.-J.; Hussain, A. Aspergillus niger CSR3 regulates plant endogenous hormones and secondary metabolites by producing gibberellins and indoleacetic acid. J. Plant Interact. 2018, 13, 100–111. [Google Scholar] [CrossRef]
- Yoo, S.-J.; Shin, D.J.; Won, H.Y.; Song, J.; Sang, M.K. Aspergillus terreus JF27 promotes the growth of tomato plants and induces resistance against Pseudomonas syringae pv. tomato. Microbiology 2018, 46, 147–153. [Google Scholar] [CrossRef]
- Xie, Y.; Li, X.; Huang, X.; Han, S.; Amombo, E.; Wassie, M.; Chen, L.; Fu, J. Characterization of the Cd-resistant fungus Aspergillus aculeatus and its potential for increasing the antioxidant activity and photosynthetic efficiency of rice. Ecotoxicol. Environ. Saf. 2019, 171, 373–381. [Google Scholar] [CrossRef]
- Mehmood, A.; Hussain, A.; Irshad, M.; Hamayun, M.; Igbal, A.; Khan, N. In vitro producing of IAA by endophytic fungus Aspergillus awamori and its growth promoting activities in Zea mays. Symbiosis 2019, 77, 225–235. [Google Scholar] [CrossRef]
- El-Maraghy, S.S.; Tohamy, T.A.; Hussein, K.A. Role of plant-growth promoting fungi (PGPF) in defensive genes expression of Triticum aestivum against wilt disease. Rhizosphere 2020, 15, 100223. [Google Scholar] [CrossRef]
- Daigham, G.E.; Mahfouz, A.Y.; Abdelaziz, A.M.; Nofel, M.M.; Attia, M.S. Protective role of plant growth-promoting fungi Aspergillus chevalieri OP593083 and Aspergillus egyptiacus OP593080 as biocontrol approach against Alternaria leaf spot disease of Vicia faba plant. Biomass Conv. Bioref. 2023. [Google Scholar] [CrossRef]
- Mundim, G.D.; Maciel, G.M.; Mendes, G.D. Aspergillus niger as a biological input for improving vegetable seedling production. Microorganisms 2022, 10, 674. [Google Scholar] [CrossRef] [PubMed]
- Escobar Diaz, P.A.; Gil, O.J.A.; Barbosa, C.H.; Desolgnies, N.; Rigobelo, E.C. Aspergillus spp. and Bacillus spp. as growth promoters in cotton plants under greenhouse conditions. Front. Sustain. Food Syst. 2021, 5, 709267. [Google Scholar] [CrossRef]
- Bernardo, L.; Morcia, C.; Carletti, P.; Ghizzoni, R.; Badeck, F.W.; Rizza, F.; Lucini, L.; Terzi, V. Proteomic insight into the mitigation of wheat root drought stress by arbuscular mycorrhizae. J. Proteom. 2017, 169, 21–32. [Google Scholar] [CrossRef] [PubMed]
- Hochholdinger, F.; Marcon, C.; Baldauf, J.A.; Yu, P.; Frey, F.P. Proteomics of maize root development. Front. Plant Sci. 2018, 9, 143. [Google Scholar] [CrossRef]
- Liu, Y.; Lu, S.; Liu, K.; Wang, S.; Huang, L.; Guo, L. Proteomics: A powerful tool to study plant responses to biotic stress. Plant Methods 2019, 15, 135. [Google Scholar] [CrossRef]
- Song, F.; Qi, D.; Liu, X.; Kong, X.; Gao, Y.; Zhou, Z.; Wu, Q. Proteomic analysis of symbiotic proteins of Glomus mosseae and Amorpha fruticose. Sci. Rep. 2016, 5, 18031. [Google Scholar] [CrossRef]
- Suthinon, P.; Rungwattana, K.; Suwanphakdee, C.; Himaman, W.; Lueangjaroenkit, P. Endophytic Fungi from Root of Three Lady’s Slipper Orchids (Paphiopedilum spp.) in Southern Thailand. Chiang Mai J. Sci. 2021, 48, 853–866. [Google Scholar]
- Klich, M.A. Identification of Common Aspergillus Species; Cenraalburaue voor Schimmelcultures: Utrecht, The Netherlands, 2002; 116p. [Google Scholar]
- Lueangjaroenkit, P.; Teerapatsakul, C.; Chitradon, L. Morphological characteristic regulation of ligninolytic enzyme produced by Trametes polyzona. Mycobiology 2018, 46, 396–406. [Google Scholar] [CrossRef] [PubMed]
- Tamura, K.; Peterson, D.; Peterson, N.; Stecher, G.; Nei, M.; Kumar, S. MEGA5: Molecular evolutionary genetics analysis using maximum likelihood, evolutionary distance, and maximum parsimony methods. Mol. Biol. Evol. 2011, 28, 2731–2739. [Google Scholar] [CrossRef] [PubMed]
- Saengket, M.; Hyde, K.D.; Kumar, V.; Doilom, M.; Brooks, S. Endophytic fungi from Oncosperma sp. with promising in vitro plant growth promotion and antagonistic activities. Chiang Mai J. Sci. 2021, 48, 837–852. [Google Scholar]
- Pikovskaya, R.I. Mobilization of phosphate in soil in connection with the vital activity of some microbial species. Mikrobiologiya 1948, 17, 362–370. [Google Scholar]
- Doilom, M.; Guo, J.-W.; Phookamsak, R.; Mortimer, P.E.; Karunarathna, S.C.; Dong, W.; Liao, C.-F.; Yan, K.; Pem, D.; Suwannarach, N.; et al. Screening of Phosphate-Solubilizing Fungi from Air and Soil in Yunnan, China: Four Novel Species in Aspergillus, Gongronella, Penicillium, and Talaromyces. Front. Microbiol. 2020, 11, 585215. [Google Scholar] [CrossRef] [PubMed]
- Zhu, J.-N.; Yu, Y.-J.; Dai, M.-D.; Zeng, Y.-L.; Lu, X.-J.; Wang, L.; Liu, X.-H.; Su, Z.-Z.; Lin, F.-C. A New Species in Pseudophialophora from Wild Rice and Beneficial Potential. Front. Microbiol. 2022, 13, 845104. [Google Scholar] [CrossRef] [PubMed]
- Aron, D. Copper enzymes isolated chloroplasts, polyphenoloxidase in Beta vulgaris. Plant Physiol. 1949, 24, 1–15. [Google Scholar] [CrossRef]
- Leetanasaksakul, K.; Roytrakul, S.; Phaonakrop, N.; Kittisenachai, S.; Thaisakun, S.; Srihuanok, N.; Sriroth, K.; Soulard, L. Discovery of potential protein biomarkers associated with sugarcane white leaf disease susceptibility using a comparative proteomics approach. PeerJ 2022, 10, e12740. [Google Scholar] [CrossRef]
- Lowry, O.H.; Rosebrough, N.J.; Farr, A.l.; Randall, R.J. Protein measurement with the folin phenol reagent. J. Biol. Chem. 1951, 193, 265–275. [Google Scholar] [CrossRef]
- Tyanova, S.; Temu, T.; Cox, J. The MaxQuant computational platform for mass spectrometry-based shotgun proteomics. Nat. Protoc. 2016, 11, 2301–2319. [Google Scholar] [CrossRef]
- Aquilan, J.T.; Kulej, K.; Sidoli, S. Guide for protein fold change and p-value calculation for non-experts in proteomics. Mol. Omics 2020, 16, 573–582. [Google Scholar] [CrossRef] [PubMed]
- Bardou, P.; Mariette, J.; Escudié, F.; Djemiel, C.; Kloopp, C. jvenn: An interactive Venn diagram viewer. BMC Bioinform. 2014, 15, 293. [Google Scholar] [CrossRef] [PubMed]
- Goedhart, J.; Luijsterburg, M.S. VolcaNoseR is a web app for creating, exploring, labeling and sharing volcano plots. Sci. Reps. 2020, 10, 20560. [Google Scholar] [CrossRef]
- Bais-Moleman, A.L.; Schulp, C.J.E.; Verberg, P.H. Assessing the environmental impacts of production- and consumption-side measures in sustainable agriculture intensification in the European Union. Geoderme 2019, 338, 555–567. [Google Scholar] [CrossRef]
- Montoya-Martínez, A.C.; Parra-Cota, F.I.; de los Santos-Villalobos, S. Beneficial Microorganisms in Sustainable Agriculture: Harnessing Microbes’ Potential to Help Feed the World. Plants 2022, 11, 372. [Google Scholar] [CrossRef]
- Baron, N.C.; Rigobelo, E.C. Endophytic fungi: A tool for plant growth promotion and sustainable agriculture. Mycology 2022, 13, 39–55. [Google Scholar] [CrossRef]
- Larran, S.; Perelló, A.; Simón, M.R. The endophytic fungi from wheat (Triticum aestivum L.). World J. Microbiol. Biotechnol. 2007, 23, 565–572. [Google Scholar] [CrossRef]
- Argumedo-Delira, R.; Gómez-Martínez, M.J.; Mora-Delgado, J. Plant growth promoting filamentous fungi and their application in the fertilization of pastures for animal consumption. Agronomy 2022, 12, 3033. [Google Scholar] [CrossRef]
- do Prado, D.Z.; Okino-Delgado, C.H.; Zanutto-Elgui, M.R.; da Silva, R.B.G.; Pereira, M.S.; Jahn, L.; Ludwig-Müller, J.L.; da Silva, M.R.; Velini, E.D.; Fleuri, L.F. Screening of Aspergillus, Bacillus and Trichoderma strains and influence of substrates on auxin and phytases production through solid-state fermentation. Biocatal. Agric. Biotechnol. 2019, 19, 101165. [Google Scholar] [CrossRef]
- Ratnam, D.P.S.K. Indole 3-acetic acid production by Aspergillus species isolated from chilli rhizospheres. Biosci. Biotechnol. Res. Commun. 2020, 13. [Google Scholar] [CrossRef]
- Sarkar, S.; Dey, A.; Kumar, V.; Batiha, G.E.; El-Eswi, M.A.; Tomczyk, M.; Ray, R. Fungal endophyte: And interactive endosymbiont with the capability of modulating host physiology in Myriad ways. Front Plant Sci. 2021, 12, 701800. [Google Scholar] [CrossRef] [PubMed]
- Miranda, V.; Silva-Castro, G.A.; Ruiz-Lozano, J.M.; Franchia, S.; García-Romera, I. Fungal endophytes enhance wheat and tomato drought tolerance in terms of plant growth and biochemical parameters. J. Fungi 2023, 9, 384. [Google Scholar] [CrossRef]
- Ray, T.; Pandey, S.S.; Pandey, A.; Srivastava, M.; Shanker, K.; Kalra, A. Endophytic consortium with diverse gene-regulating capabilities of benzylisoquinoline alkaloids biosynthetic pathway can enhance endogenous morphine biosynthesis in Papaver somniferum. Front. Microbiol. 2019, 10, 925. [Google Scholar] [CrossRef] [PubMed]
- Verma, V.; Batta, A.; Singh, H.B.; Srivastava, A.; Garg, S.K.; Singh, V.P.; Arora, P.K. Bioenginerring of fungal endophytes through the CRISPR/Cas9 system. Front. Microbiol. 2023, 14, 1146650. [Google Scholar] [CrossRef] [PubMed]
- Wei, K.; Chen, H. Comparative functional genomics analysis of bHLH gene family in rice, maize and wheat. BMC Plant Biol. 2018, 18, 309. [Google Scholar] [CrossRef] [PubMed]
- Song, C.; Cao, Y.; Dai, J.; Li, G.; Manzoor, M.A.; Chen, C.; Den, H. The multifaceted roles of MYC2 in plants: Toward transcriptional reprogramming and stress tolerance by fasmonate signaling. Front. Plant Sci. 2022, 13, 868874. [Google Scholar] [CrossRef] [PubMed]
- Ji, X.; Xia, Y.; Zhang, H.; Cui, J.-L. The microscopic mechanism between endophytic fungi and host plants: From recognition to building stable mutually beneficial relationships. Microbiol. Res. 2022, 261, 127056. [Google Scholar] [CrossRef] [PubMed]
- Yuan, J.; Zhang, W.; Sun, K.; Tang, M.-J.; Chen, P.-X.; Li, X.; Dai, C.-C. Comparative transcriptomics and proteomics of Atractylodes landea in response to endophytic fungus Gilmaniella sp. AL12 reveals regulation in plant metabolism. Front. Microbiol. 2019, 10, 1208. [Google Scholar] [CrossRef] [PubMed]
- Ortiz, J.; Soto, J.; Fuentes, A.; Herrera, H.; Meneses, C.; Arriagada, C. The endophytic fungus Chaetomium cupreum regulates expression of genes involved in the tolerance to metals and plant growth promotion in Eucalyptus globulus roots. Microorganisms 2019, 7, 490. [Google Scholar] [CrossRef]
- Weijers, D.; Benkova, E.; Jäger, K.E.; Schlereth, A.; Hamann, T.; Kientz, M.; Wilmoth, J.C.; Reed, J.W.; Jürgens, G. Developmental specificity of auxin response by pairs of ARF and Aux/IAA transcriptional regulators. EMBO J. 2005, 24, 1874–1885. [Google Scholar] [CrossRef]
- Paque, S.; Weijers, D. Q&A: Auxin: The plant molecule that influences almost anything. BMC Biol. 2016, 14, 67. [Google Scholar]
- Zenser, N.; Ellsmore, A.; Leasure, C.; Callis, J. Auxin modulates the degradation rate of Aux/IAA proteins. Proc. Natl. Acad. Sci. USA 2001, 98, 11795–11800. [Google Scholar] [CrossRef] [PubMed]
- Paponov, I.A.; Paponov, M.; Teale, W.; Menges, M.; Chakrabortee, S.; Murray, J.A.H.; Palme, K. Comprehensive transcriptome analysis of auxin responses in Arabidopsis. Mol. Plant 2008, 1, 321–337. [Google Scholar] [CrossRef] [PubMed]
- Li, H.; Tiwari, S.B.; Hagen, G.; Guifoyle, T.J. Identical amino acid substitutions in the repression domain of auxin/indole-3-acetic acid proteins have contrasting effects on auxin signaling. Plant Physiol. 2011, 155, 1252–1263. [Google Scholar] [CrossRef] [PubMed]
- Eckardt, N.A. Auxin and the power of the proteasome in plants. Plant Cell. 2001, 13, 2161–2164. [Google Scholar] [CrossRef] [PubMed]
- Shalygo, N.; Czarnecki, O.; Peter, E.; Grimm, B. Expression of chlorophyll synthase is also involved in feedback-control of chlorophyll biosynthesis. Plant Mol. Biol. 2009, 71, 425–436. [Google Scholar] [CrossRef] [PubMed]
- Zhang, D.; Chang, E.; Yu, X.; Chen, Y.; Yang, Q.; Cao, Y.; Li, X.; Wang, Y.; Fu, A.; Xu, M. Molecular characterization of magnesium chelatase in soybean [Glycine max (L.) Merr.]. Front. Plant Sci. 2018, 9, 720. [Google Scholar] [CrossRef] [PubMed]
- Masuda, T. Recent overview of the Mg branch of the tetrapyrrole biosynthesis leading to chlorophylls. Photosynth. Res. 2008, 96, 121–143. [Google Scholar] [CrossRef]
- Wu, F.-Q.; Xin, Q.; Cao, Z.; Liu, Z.-Q.; Du, S.-Y.; Mei, C.; Zhao, C.-X.; Wang, X.-F.; Shang, Y.; Jiang, T.; et al. The magnesium-chelatase H subunit binds abscisic acid and functions in abscisic acid signaling: New evidence in Arabidopsis. Plant Physiol. 2009, 150, 1940–1954. [Google Scholar] [CrossRef]
- Xu, X.; Ouyang, M.; Lu, D.; Zheng, C.; Zhang, L. Protein sorting with chloroplasts. Trends Cell Biol. 2021, 31, 9–16. [Google Scholar] [CrossRef]
- Ouyang, M.; Li, X.; Ma, J.; Chi, W.; Xiao, J.; Zou, M.; Chen, F.; Lu, C.; Zhang, L. LTD is a protein required for sorting light-harvesting chlorophyll-binding proteins to the chloroplast SRP pathway. Nat. Commun. 2011, 2, 277. [Google Scholar] [CrossRef]
- Overvoorde, P.J.; Okushima, Y.; Alonso, J.M.; Chan, A.; Chang, C.; Ecker, J.R.; Hughes, B.; Liu, A.; Onodera, C.; Quach, H.; et al. Functional genomic analysis of the auxin/indole-3-acetic acid gene family members in Arabidopsis thaliana. Plant Cell. 2005, 17, 3282–3300. [Google Scholar] [CrossRef]
- Wang, P.; Li, C.; Wang, Y.; Huang, R.; Sun, C.; Xu, C.; Xu, Z.; Zhu, J.; Gao, X.; Deng, X.; et al. Identification of a geranylgeranyl reductase gene for chlorophyll synthesis in rice. SpringerPlus 2014, 3, 201. [Google Scholar] [CrossRef]
- Camagna, M.; Grundmann, A.; Bär, C.; Koschmieder, J.; Beyer, P.; Welsch, R. Enzyme fusion removes competition for geranylgeranyl diphosphate in carotenogenesis. Plant Physiol. 2019, 179, 1013–1027. [Google Scholar] [CrossRef]
- Giannino, D.; Condello, E.; Bruno, L.; Testone, G.; Tartarini, A.; Cozza, R.; Innocenti, A.M.; Bitonti, M.B.; Mariotti, D. The gene geranylgeranyl reductase of peach (Prunus persica [L.] Batsch) is regulated during leaf development and responds differentially to distinct stress factors. J. Exp. Bot. 2004, 55, 2063–2073. [Google Scholar] [CrossRef] [PubMed]
- Pružinská, A.; Anders, I.; Aubry, S.; Schenk, N.; Tapernoux-Lüthi, E.; Müller, T.; Kräutler, B.; Hörtensteiner, S. In vivo participation of red chlorophyll catabolite reductase in chlorophyll breakdown. Plant Cell. 2007, 19, 369–387. [Google Scholar] [CrossRef] [PubMed]
- Siebenaller, C.; Junglas, B.; Schneider, D. Functional implications of multiple IM30 oligomeric states. Front Plant Sci. 2019, 10, 1500. [Google Scholar] [CrossRef] [PubMed]
- Rehman, H.M.; Chen, S.; Zhang, S.; Khalid, M.; Uzair, M.; Wilmarth, P.A.; Ahmad, S.; Lam, H.-M. Membrane proteomic profiling of soybean leaf and root tissue uncovers salt-tress-responsive membrane protein. Int. J. Mol. Sci. 2022, 23, 13270. [Google Scholar] [CrossRef]

| Protein ID | Function/Component | Protein Name | Peptide Sequence | p-Value | Log2 (Fold-Change) |
|---|---|---|---|---|---|
| Leaf | |||||
| B9G2A8 | Auxin polar transport/Membrane | Auxin transport protein BIG | AAVGHLR | 0.03 | 2.09 |
| Q5NB25 | Auxin-activated signaling pathway/Nucleus | Auxin-responsive protein IAA3 (Indoleacetic acid-induced protein 3) | AAREGEEVGAEEEDKK | 0.03 | 10.01 |
| Q6H6V4 | Auxin response factor 6 (OsARF6a) | DLHGNEWKFRHIFR | 0.04 | 8.05 | |
| Q75GB1 | Auxin-responsive protein IAA14 (Indoleacetic acid-induced protein 17) | AAAGEEDEDAEEEDK | 0.00 | −5.73 | |
| Q5W6H5 | Chlorophyll biosynthetic process/Chloroplast | Chlorophyll synthase, chloroplastic (EC2.5.1.62) (Polyprenyl transferase) | GAKQENDIWK | 0.00 | 12.69 |
| Q10M50 | Magnesium–chelatase subunit ChlH, chloroplastic (Mg–chelatase subunit H) (EC 6.6.1.1) (Mg–protoporphyrin IX chelatase subunit ChlH) | AAGFEVVGYLVEELRDEETYK | 0.00 | 5.94 | |
| A3BKF2 | Granum assembly/Chloroplast envelope | Protein LHCP TRANSLOCATION DEFECT | DAEGAGIYGSQGRDDFDR | 0.02 | 7.73 |
| Root | |||||
| Q10D34 | Auxin-activated signaling pathway/Nucleus | Auxin-responsive protein IAA13 (Indoleacetic acid-induced protein 13) | AEAPAAEKAK | 0.04 | −7.67 |
| P0C131 | Putative auxin-responsive protein IAA29 (Indoleacetic acid-induced protein 29) | INLALHNNYDSLSFTLK | 0.03 | −8.71 | |
| Q6L5F6 | Auxin export across the plasma membrane/Endoplasmic reticulum | Probable auxin efflux carrier component 3b (OsPIN3b) (OSPIN10b) | ASSFGAADLFSLHSSSR | 0.02 | 8.21 |
| Q6Z2T6 | Chlorophyll biosynthetic process/Chloroplast | Geranylgeranyl diphosphate reductase, chloroplastic (EC 1.3.1.83) (Geranylgeranyl reductase) | AAASSPK | 0.03 | −2.5 |
| Q338P6 | Chlorophyll catabolic process/Chloroplast | Red chlorophyll catabolite reductase 1, chloroplastic (OsRCCR1) (RCC reductase) (EC 1.3.7.12) | AFGVQEA | 0.03 | 9.79 |
| Q8S0J7 | Thylakoid membrane organization/Chloroplast inner membrane | Probable membrane-associated 30 kDa protein, chloroplastic | AQLALQK | 0.03 | 2.27 |
Disclaimer/Publisher’s Note: The statements, opinions and data contained in all publications are solely those of the individual author(s) and contributor(s) and not of MDPI and/or the editor(s). MDPI and/or the editor(s) disclaim responsibility for any injury to people or property resulting from any ideas, methods, instructions or products referred to in the content. |
© 2024 by the authors. Licensee MDPI, Basel, Switzerland. This article is an open access article distributed under the terms and conditions of the Creative Commons Attribution (CC BY) license (https://creativecommons.org/licenses/by/4.0/).
Share and Cite
Leetanasaksakul, K.; Roytrakul, S.; Kittisenachai, S.; Lohmaneeratana, K.; Jantasuriyarat, C.; Lueangjaroenkit, P. Exploring the Impact of Endophytic Fungus Aspergillus cejpii DMKU-R3G3 on Rice: Plant Growth Promotion and Molecular Insights through Proteomic Analysis. Agronomy 2024, 14, 498. https://doi.org/10.3390/agronomy14030498
Leetanasaksakul K, Roytrakul S, Kittisenachai S, Lohmaneeratana K, Jantasuriyarat C, Lueangjaroenkit P. Exploring the Impact of Endophytic Fungus Aspergillus cejpii DMKU-R3G3 on Rice: Plant Growth Promotion and Molecular Insights through Proteomic Analysis. Agronomy. 2024; 14(3):498. https://doi.org/10.3390/agronomy14030498
Chicago/Turabian StyleLeetanasaksakul, Kantinan, Sittiruk Roytrakul, Suthathip Kittisenachai, Karan Lohmaneeratana, Chatchawan Jantasuriyarat, and Piyangkun Lueangjaroenkit. 2024. "Exploring the Impact of Endophytic Fungus Aspergillus cejpii DMKU-R3G3 on Rice: Plant Growth Promotion and Molecular Insights through Proteomic Analysis" Agronomy 14, no. 3: 498. https://doi.org/10.3390/agronomy14030498
APA StyleLeetanasaksakul, K., Roytrakul, S., Kittisenachai, S., Lohmaneeratana, K., Jantasuriyarat, C., & Lueangjaroenkit, P. (2024). Exploring the Impact of Endophytic Fungus Aspergillus cejpii DMKU-R3G3 on Rice: Plant Growth Promotion and Molecular Insights through Proteomic Analysis. Agronomy, 14(3), 498. https://doi.org/10.3390/agronomy14030498

